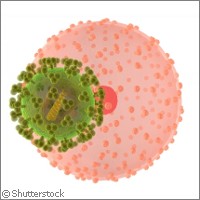

Neues HIV-Medikament für therapieresistente Affen
Österreichische, britische und amerikanische Forscher haben ein neues Medikament an SIV-infizierten Affen getestet. SIV (simian immunodeficiency virus) ist mit dem menschlichen Aids-Virus HIV verwandt. Das Medikament senkte die Viruslast bei Tieren, die nicht auf eine antiretrovirale Therapie (ART) ansprachen. Die im Fachblatt "Journal of Immunology" veröffentlichten Ergebnisse lassen hoffen, dass das Medikament in Kombination mit antiretroviralen Therapien ein Weg ist, HIV/SIV-Infektionen in den Griff zu bekommen. In der wissenschaftlichen Forschung werden SIV-infizierte Tiermodelle eingesetzt, um die Wirkung potenzieller AIDS-Medikamente zu testen. Dabei wird untersucht, ob die jeweiligen Substanzen in der Lage sind, die Viruslast im Blut der Tiere zu senken. Je höher die Viruslast beim Menschen ist, desto eher erkrankt er an AIDS, wobei der Körper Infektionen, die eigentlich unkompliziert sind, nicht mehr abwehren kann. Die momentane Standardtherapie für Menschen ist die hochaktive antiretrovirale Therapie (HAART), mit der die Viruslast im Blut der Patienten gesenkt und der Beginn der AIDS-Erkrankung hinausgezögert werden kann. Obwohl dieser Medikamentencocktail die Lebenserwartung der meisten Betroffenen deutlich verlängert, schlägt er bei 1 von 10 Patienten nicht an. Die aktuelle Forschung sucht nun nach Wegen, die Wirksamkeit solcher Cocktails bei HAART-resistenten Patienten zu verbessern. "Obwohl HIV das Leben der Betroffenen von Grund auf verändert, gilt die Erkrankung dank moderner antiretroviraler Medikamente inzwischen eher als chronisch und behandelbar", sagte Dr. Adriano Boasso vom Imperial College London im Vereinigten Königreich. "Doch leider schlägt die Therapie nicht immer an, weil manche Menschen Resistenzen gegen die Medikamente entwickeln. In solchen Fällen sind wir im Prinzip machtlos und können den Beginn der AIDS-Erkrankung nicht weiter hinauszögern." Im Rahmen der jüngsten Studie wurden 19 Rhesusaffen mit dem SI-Virus infiziert. 11 von ihnen erhielten mindestens vier Monate lang antiretrovirale Medikamente und danach zwei Wochen lang täglich die modifizierte Aminosäure D-1mT. Bei Affen, die nicht auf antiretrovirale Therapien ansprachen, senkte D-1mT die Viruslast in Plasma und Lymphknoten signifikant. Die Medikation wirkte allerdings nicht bei Tieren ohne vorherige antiretrovirale Therapie. "Die ersten Ergebnisse deuten darauf hin, dass D-1mT in Kombination mit antiretroviralen Medikamenten die Replikation des Virus stoppen kann", sagte Dr. Boasso. "Da die Virusreplikation für den Krankheitsfortschritt wesentlich ist, könnten wir durch die Verlangsamung dieses Prozesses auch die Krankheitssymptome für den Betroffenen abmildern. Zurzeit untersuchen wir noch die genaue Wirkungsweise von D-1mT, um auf dieser Basis vielleicht irgendwann ein effektives HIV-Medikament entwickeln zu können." Nach Meinung der Forscher könnte D-1mT das Immunsystem reaktivieren, weil es das Enzym IDO hemmt, mit dessen Hilfe es HI- und SI-Viren gelingt, das Immunsystem zu unterdrücken. Bei nicht infizierten Menschen sorgt IDO dafür, dass sich das Immunsystem nicht gegen den eigenen Körper richtet. Bei HIV-Infizierten hingegen übernimmt das Virus die Kontrolle über diese Maschinerie und verhindert den Angriff des Immunsystems auf das Virus. Die Forscher fanden allerdings keinerlei Hinweise darauf, dass D-1mT die Immunantwort gegen SIV reaktiviert. "Offenbar kann D-1mT die Viruslast stark reduzieren, das Ergebnis war allerdings überraschend", sagte Dr. Boasso. "Wir hatten nicht damit gerechnet, dass D-1mT nur bei Affen wirkt, die zuvor antiretroviral behandelt worden waren. Es scheint, als ob D-1mT mit ART einen synergetischen Effekt bildet, und wir wollen herausfinden, was dort genau passiert." Momentan befindet sich D-1mT in der Phase der klinischen Prüfung als Krebsmedikament. An den Ergebnissen wird sich zeigen, ob das Medikament für Menschen geeignet ist. Wenn es sich als sicher erweist und möglicherweise gegen HIV wirkt, könnten bereits 2015 Versuche mit D-1mT in HIV-Therapien beginnen.
Länder
Österreich, Vereinigtes Königreich, Vereinigte Staaten